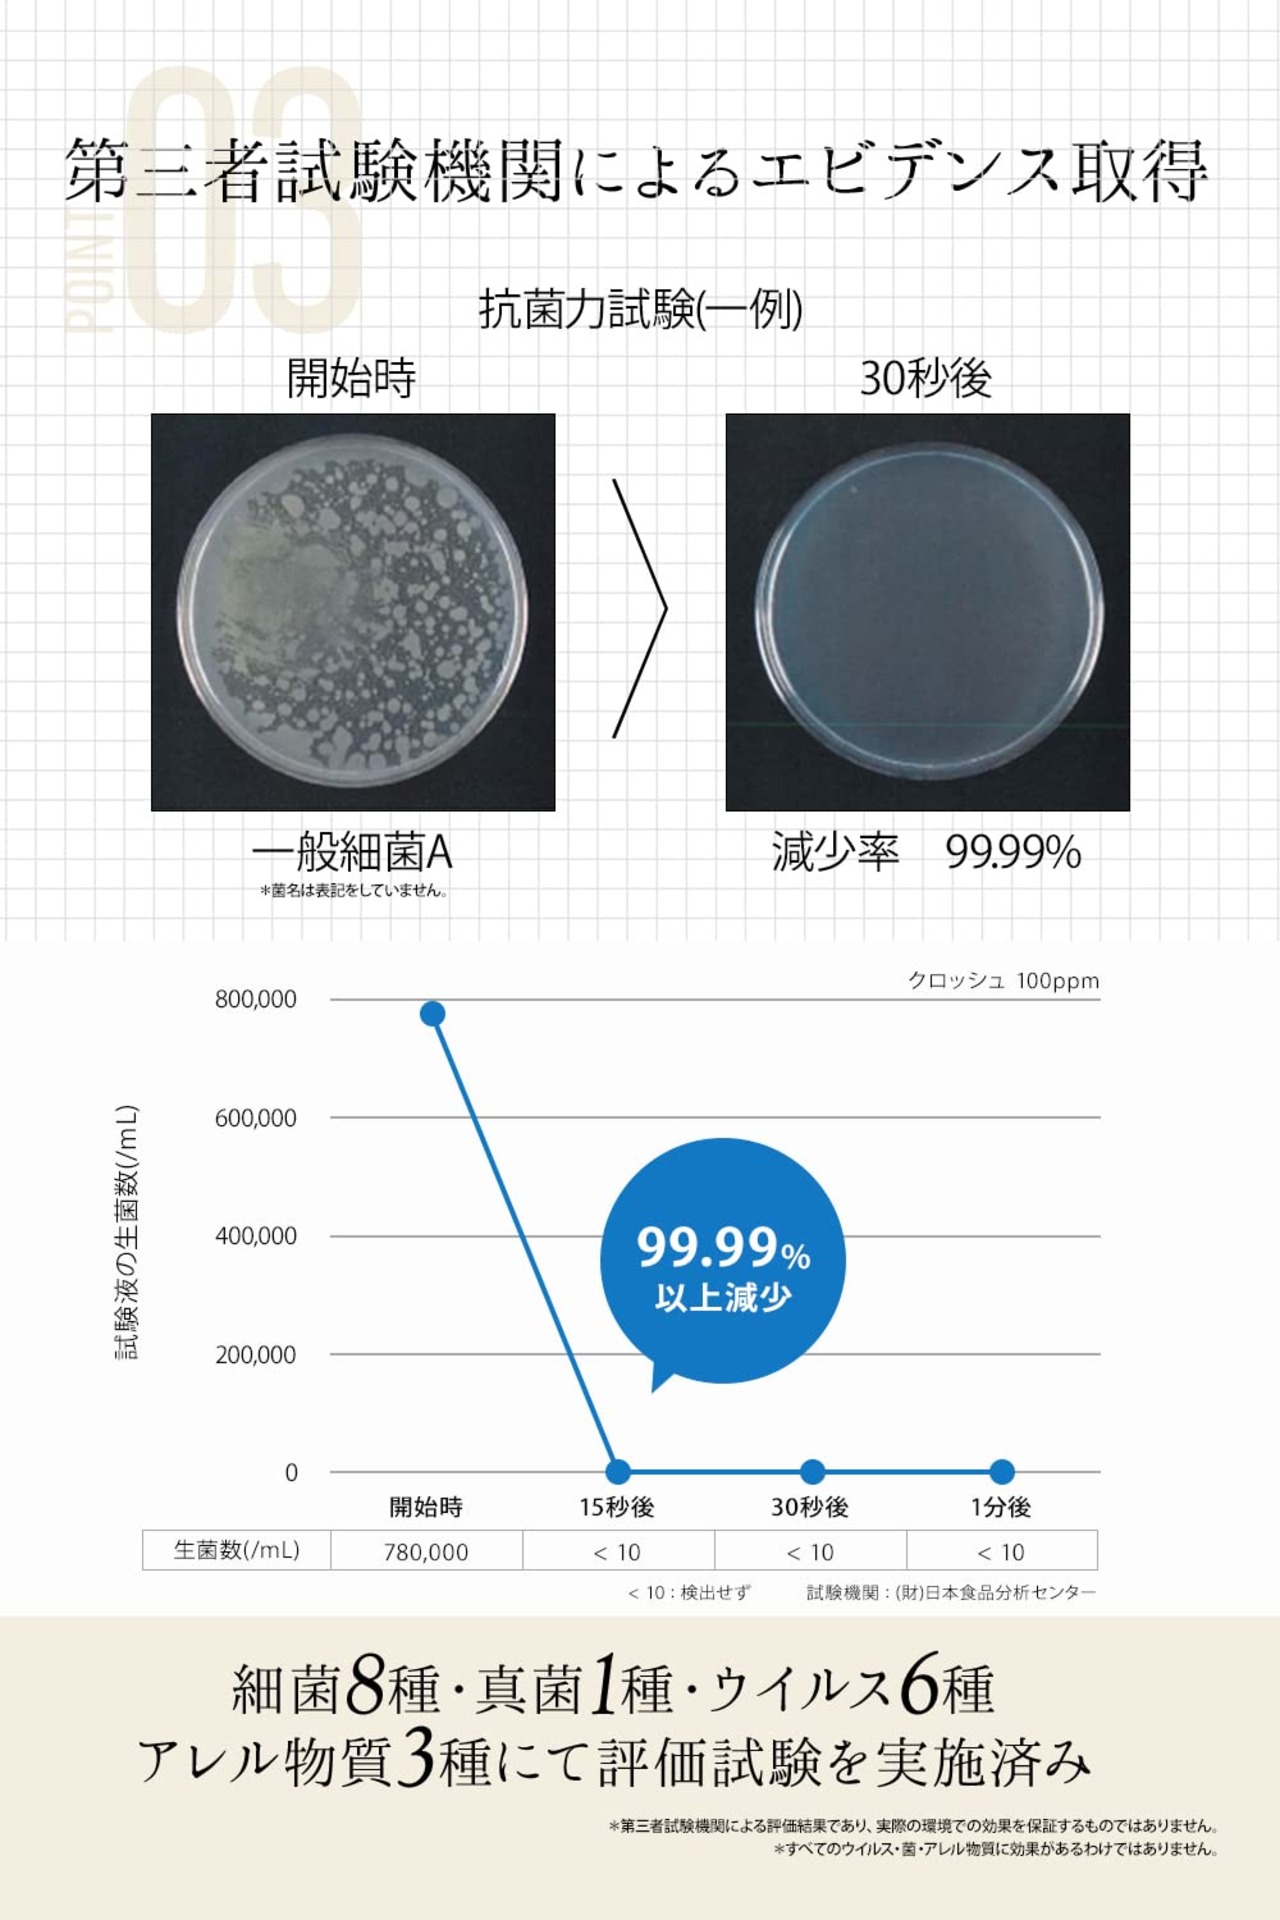

・翌月にまとめてお支払い可能
・手数料無料(口座振替の場合)
・アプリでご利用金額を確認できて安心
【2022最新】CHLOsh (クロッシュ) 超音波噴霧器用 (20L) 50ppm (安定型次亜塩素酸ナトリウム) 補充用 バッグインボックス (お部屋まるごと 空間除菌 消臭)無香料 | Lumisfera

¥21,836 税込
なら 手数料無料の 翌月払いでOK
この商品は送料無料です。
CHLOsh (クロッシュ) 超音波噴霧器用 (20L) 50ppm (安定型次亜塩素酸ナトリウム) 補充用 バッグインボックス (お部屋まるごと 空間除菌 消臭)無香料
【お徳用!大容量詰替え用途】プロの業者から、たっぷりお使いいただくユーザー向けの補充・詰替え用です。1L(ボトル、中栓付き)〜 20Lバッグインボックス(箱)入りまで、ご使用頻度に合わせてお選びください。冷暗所に保管いただければ、そのまま防災備蓄品としてお役立ていただけます。専用超音波噴霧器用の濃度50ppm品は10Lと20Lをご用意しております。
【お部屋まるごと除菌消臭】クロッシュ専用超音波噴霧器にお使いいただける詰め替えタイプ(バックインボックス)です。専用超音波噴霧器による空間噴霧で居住空間全体を清潔に保ちます。
【補充用液剤50ppm】クロッシュ専用超音波噴霧器にお使いいただける詰め替えタイプ(バックインボックス)です。専用超音波噴霧器による微細粒子での噴霧で、居住空間全体を清潔に保ちます。
【さまざまな場所で!】病院や介護施設、オフィスや幼稚園などの人が集まる場所。ご家庭のリビングやベッドルームの滞留する空気・床・壁・テーブルやソファーなどお部屋全体を清潔に保ちます。金属製品に対する腐食や繊維に対する漂白作用もほぼ水程度なので安心してご使用頂けます。
クロッシュ専用超音波噴霧器用液剤、濃度:50ppm、容量:20L、バッグインボックス(箱)入り、S字コック付
ブランド CHLOSH(クロッシュ)
商品の形状 液体
香り 無香料
商品用途・使用方法 all_purpose
素材の特徴 毒性のない
商品体積 1000 ミリリットル
ユニット数 20000.0 ミリリットル
推奨使用場所 壁, 床
表示を増やす
送料・配送方法について
お支払い方法について